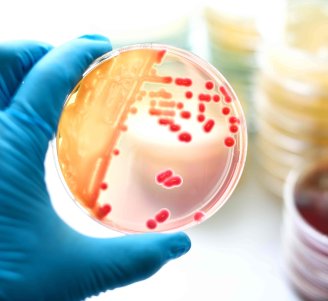
Culture de bactérie en boîte de Pétri - Crédit jarun011

Bt ID
Qualité, Bacillus thuringiensis, Bt, Bacillus cereus présomptif, contaminations, phytosanitaire
Outils pour identifier, tracer et contrôler les contaminations de Bacillus thuringiensis de la fourche à la fourchette.
Descriptif du projet
Objectifs du projet
Bacillus thuringiensis ou Bt est une bactérie ubiquiste utilisée en agriculture, et notamment en agriculture biologique, pour ses propriétés insecticides.
Au niveau taxonomique, Bt appartient au groupe de Bacillus cereus sensu lato. Ce groupe au sens large, dont les différentes espèces sont difficiles à différencier par les méthodes classiques de microbiologie, contient également des bactéries qui peuvent poser des problèmes sanitaires et entrainer des toxi-infections alimentaires collectives (TIAC). De ce fait, il existe un seuil d'alerte pour le dénombrement total des bactéries de ce groupe. Or, ce seuil peut être atteint voire dépassé lors des traitements phytosanitaires à base de Bt.
Ce projet visait à :
1. Proposer des recommandations sur l'utilisation de ces produits phytosanitaires pour les cultures étudiées (choix, temps d'action, délai avant récolte à respecter, etc...) ;
2. Caractériser la diversité de B. thuringiensis pour situer les souches commerciales au sein du groupe B. cereus et tracer les contaminations par Bacillus thuringiensis des végétaux aux produits finis par l'utilisation de méthodes analytiques robustes, répétables et reproductibles ;
3. Développer un portail internet donnant accès aux livrables, recommandations et outils d'aide à la décision (OAD) pour qualifier les risques sanitaires et d'altération associés aux contaminations du groupe B. cereus.
Rôle de l’ITAB dans le projet
Chef de file
PRODUCTIONS DU PROJET

État du projet
Terminé
Administratif du projet
Structure chef de file
ITAB
Chef de projet de la structure
Rodolphe Vidal
Date de début/Date de fin
2016 / 2019
Financé par
Casdar
Pour un coût total de
616 464 €
En partenariat avec
- ANSES
- IBB
- INRA
- ADRIA : institut technique agro-industriel (Quimper)
- LABOCEA
- GIP regroupant trois laboratoires de référence (Quimper et sa région)
- LUBEM, laboratoire universitaire (Quimper)

Échelle du projet
Nationale



